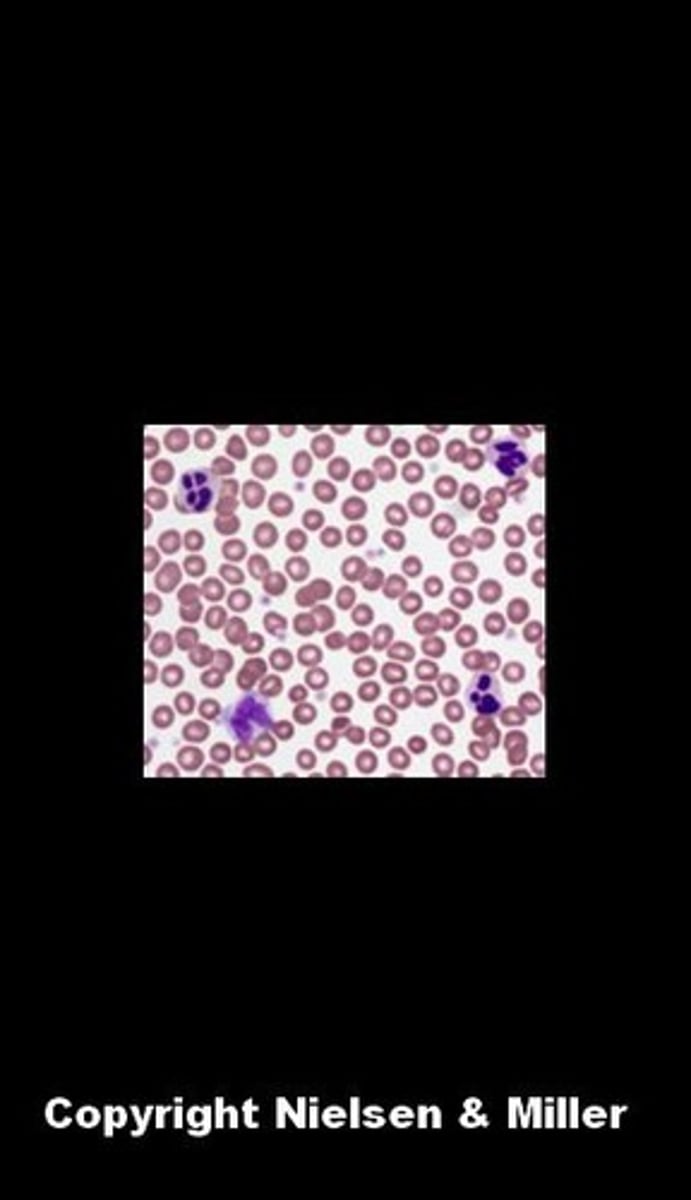
knowt flashcard image

ANAT 100 Practical Lab 1
1/149
There's no tags or description
Looks like no tags are added yet.
Name | Mastery | Learn | Test | Matching | Spaced | Call with Kai |
|---|
No analytics yet
Send a link to your students to track their progress
150 Terms
acetabulum

acromion

anatomical neck of the humerus

arachnoid mater

areolar connective tissue

atlas (C1)

axial skeleton

axis (C2)

biceps brachii

blood connective tissue
bone connective tissue

brain

capitulum

cauda equina

cerebellum

cerebral hemispheres

cerebrum

clavicle

collagen fibres

coracoid process

deltoid

dens

dense irregular connective tissue

dense regular connective tissue

dura mater

elastic fibres

elastic cartilage

extensor carpi radialis longus

extensor carpi ulnaris

external auditory meatus

external intercostals

external obliques

femur

fibrocartilage

fibularis (peroneus) longus

flexor carpi radialis

flexor carpi ulnaris

metatarsals

phalanges (foot)

foramen magnum

fourth ventricle

frontal bone

gastrocnemius

glenoid fossa

gluteus maximus

gluteus medius

gluteus minimus

greater sciatic notch

ground substance

metacarpals

phalanges (hand)

head of femur

head of fibula

head of humerus

head of radius

head of ulna

humerus

hyaline cartilage

hypothalamus

infraspinatus

internal intercostals

internal obliques

intervertebral discs

lateral condyle of femur

lateral condyle of tibia

lateral epicondyle

lateral malleolus

lateral masses

lateral ventricles

latissimus dorsi

lesser sciatic notch

mandible

masseter

mastoid process

maxilla

medial condyle of femur

medial condyle of tibia

medial epicondyle

medial malleolus

medulla oblongata

midbrain

nasal bone

neck of femur

neck of fibula

neck of radius

nervous tissue

obturator foramen

occipital bone

occipital condyles

olecranon fossa

orbicularis oculi

orbicularis oris

parietal bone

patella

pectoralis major

pectoralis minor

perichondrium

pia mater

pons

pseudostratified columnar epithelium
